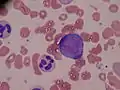

Promyelocyte
A promyelocyte (or progranulocyte) is a granulocyte precursor, developing from the myeloblast and developing into the myelocyte. Promyelocytes measure 12-20 microns in diameter. The nucleus of a promyelocyte is approximately the same size as a myeloblast but their cytoplasm is much more abundant.[1] They also have less prominent nucleoli than myeloblasts and their chromatin is more coarse and clumped.[1] The cytoplasm is basophilic and contains primary red/purple granules.[1]
| Promyelocyte | |
|---|---|
| Details | |
| Precursor | Myeloblast |
| Gives rise to | Myelocyte |
| Location | Bone marrow |
| Identifiers | |
| TH | H2.00.04.3.04003 |
| Anatomical terms of microanatomy | |

Basophilic promyelocyte

Eosonophilic promyelocyte

Neutrophilic promyelocyte
Additional images
Promyelocyte from bone marrow examination
Promyelocyte from bone marrow examination_diagram_en.svg.png.webp) Hematopoiesis
Hematopoiesis
References
- "Promyelocyte - LabCE.com, Laboratory Continuing Education". www.labce.com. Retrieved 2018-11-21.
External links
- Histology image: 01806loa – Histology Learning System at Boston University - "18. Bone Marrow and Hemopoiesis: bone marrow smear, promyelocyte and erythroblasts "
- Histology at KUMC blood-blood08 "Bone marrow"
- Histology at KUMC blood-blood11 "Bone marrow"
- "White Cell Basics: Maturation" at virginia.edu
- Histology image: 75_02 at the University of Oklahoma Health Sciences Center - "Bone marrow smear"
- Promyelocyte at the US National Library of Medicine Medical Subject Headings (MeSH)
This article is issued from Wikipedia. The text is licensed under Creative Commons - Attribution - Sharealike. Additional terms may apply for the media files.